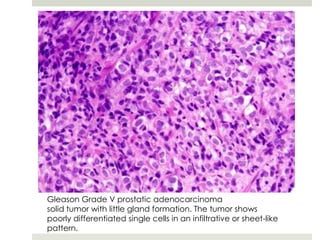
Gleason Grade V prostatic adenocarcinoma
solid tumor with little gland formation. The tumor shows
poorly differentiated single cells in an infiltrative or sheet-like
pattern.

Chemical carcinogenesis involves multiple stages: initiation, promotion, and progression. Initiation involves DNA damage from mutagenic chemicals and fixes a heritable mutation. Promotion involves clonal expansion of initiated cells. Progression leads to malignant tumors through additional mutations. Initiation is irreversible while promotion and progression are reversible. Carcinogens are classified as genotoxic if they directly damage DNA or non-genotoxic if they modify gene expression without direct DNA damage. The multi-stage model of carcinogenesis with initiation, promotion and progression explains the process at a molecular level.

![7,12-Dimethylbenz[a]anthracene two-hit experimental design in FVB/N mice.
DMBA is a classical initiator; TPA is a classical promoter.
What would you predict the outcome is for each experimental group?](https://image.slidesharecdn.com/nicnascarcinogenesis9-130126235508-phpapp02/85/Nicnas-carcinogenesis9-43-320.jpg)




























![Molecular Basis of Carcinogesis:
Fundamental Principles
Non-lethal genetic damage (mutation) is the foundation
of carcinogenesis;
Source of mutation can be environmental
(chemical, physical or infectious [viruses]);
Source of the mutation can be inherited;
Can be due to chance (spontaneous and stochastic);
A neoplasm is formed by the clonal expansion of a single
precursor cell that has incurred genetic damage (i.e.
neoplasms are monoclonal);](https://image.slidesharecdn.com/nicnascarcinogenesis9-130126235508-phpapp02/85/Nicnas-carcinogenesis9-72-320.jpg)
















































































































![The Warburg Effect
Even in the presence of ample oxygen, neoplastic cells are
heavily dependent upon anerobic glycolysis rather than
mitochondria for energy production;
Cancers have very high glucose requirements compared with
normal tissues (taken advantage of in some imaging and drug
targeting regimes [PET imaging]);
Warburg effect is assumed to provide neoplastic cells a growth
advantage in relatively hypoxic tumor environments (despite
angiogenesis, most cancers remain relatively hypoxic);](https://image.slidesharecdn.com/nicnascarcinogenesis9-130126235508-phpapp02/85/Nicnas-carcinogenesis9-185-320.jpg)









































































